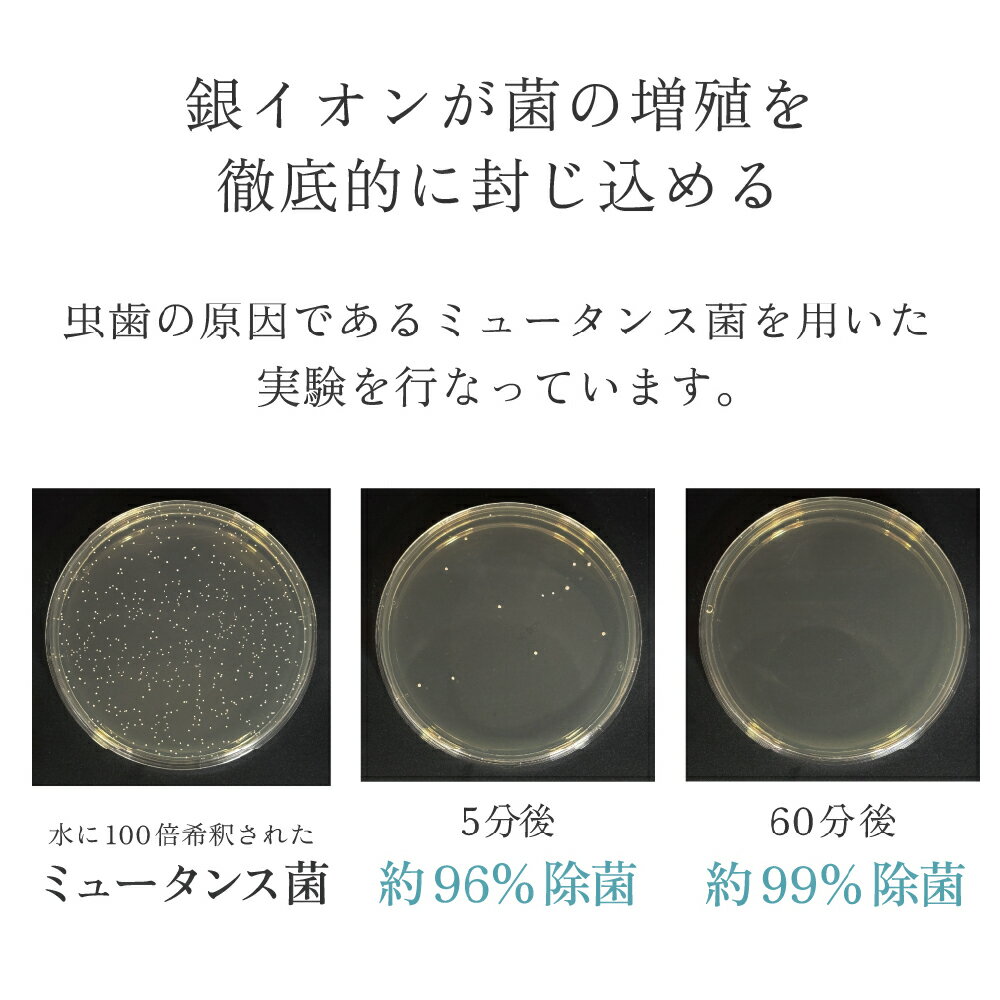
thum3

価格の安い順に表示する | 価格の高い順に表示する | 新着順に表示する | 人気順に表示する


ライオン チェックアップ スタンダード 1450ppm マイルドピュアミント 135g 全国一律送料無料
LION CheckUPスタンダードは、フッ素が再石灰化を促進し、脱灰を抑制してう蝕の発生・進行を予防します。 低研磨、低発泡、低香味のソフトペーストタイプで、長時間のブラッシングに適しています. 〇医薬部外品 〇歯科用 〇内容量:135g 〇販売者:ライオン歯科株式会社 全国一律送料無料低研磨、低発泡、低香味のソフトペーストタイプで
大久保薬局
738円(税込) (送料込) (カード利用可)
レビュー件数: 2 平均評価: 5




ジェムペースト 歯磨きジェル 65g 全成分天然由来 無添加 フッ素なし 歯磨き粉 研磨剤不使用 口臭ケア
海水と植物から採取したミネラルに特殊な振動を与えるバイオミネラルを採用!マウスウォッシュとしても
商品情報商品名ジェムペースト内容量65g原材料水(溶剤)、グリセリン(湿潤材)、セルロースガム(粘度調整剤)、ミネラル塩(矯味剤)、キシリトール(甘味料)、メントール(清涼剤)、海塩(矯味剤)、ステビア葉/茎エキス(矯味剤)、グレープフルーツ種子エキス(矯味剤)、炭酸水素Na(清掃剤)、含水シリカ(清掃剤)、アロエエキス(保湿剤)、ローズマリー葉エキス(保湿剤)、グリチルリチン酸2K(矯味剤)、ヒ...
JUN WORLD 楽天市場店
2,480円(税込) (送料込) (カード利用可)
レビュー件数: 2 平均評価: 4.5


送料無料!
1個4個セット※商品リニューアル等によりパッケージ及び容量は変更となる場合があります。ご了承ください。 商品名 シティースホワイト しみないケア 内容量 110g 商品説明(製品の特徴) 製薬会社のオーラルケア研究から生まれた美白高機能歯みがきシリーズ美白で自信 輝く白い歯へ(1)トリプルステインオフ処方でステイン(着色汚れ)を浮かせて落とす。(2)再石灰化を促進し、歯の表面を強くなめらかに。(3...
クスリのアオキ楽天市場店
6,918円(税込) (送料込) (カード利用可)
レビュー件数: 2 平均評価: 5




リペリオ 薬用歯磨剤 歯みがき粉【2本】+携帯用5g【2本】付き 歯肉炎 歯周病予防
ウエルテック 歯周病予防 口臭予防 歯ぐきが赤く腫れている 歯ぐきから血がでる 歯ぐきのやせを防ぎたい サンプル マイルドミント
●製品特長 歯肉の腫れ、出血、歯肉退縮は、トラブルのサインです。 リペリオは歯周病や加齢によって傷んだ歯肉の改善を促すハミガキ。 引き締まった、健康な歯肉に導きます。 ●歯周組織の回復を促進 OIM加水分解コンキオリンが加齢や歯周病によって 下がった歯周組織の回復を促します。 ●歯肉をキュッと引き締める 塩化ナトリウム配合。 ブラッシング中に歯肉の血行を促進し、歯肉を引き締めます。 ●発泡剤無配合...
health lab ひよこ堂
2,748円(税込) (送料込) (カード利用可)
レビュー件数: 2 平均評価: 5




エスケー石鹸 薬用ソルトハミガキ140g ×8本 歯みがき 歯磨き粉 SK 石けん せっけん 石鹸 合成界面活性剤不使用 無添加 ソルト 歯磨き粉
薬用ソルトハミガキ140g ×8本 歯磨き粉 無添加塩ハミガキ
名称エスケー石鹸 薬用ソルトハミガキ ×8本 内容量140g使用成分研磨剤 :炭酸カルシウム ,湿潤剤:濃グリセリン、ソルビット液,有効成分:塩化ナトリウム、グリチルリチン酸ジカリウム,粘度調整剤:無水ケイ酸、キサンタンガム,香味剤:香料(ペパーミントタイプ)保存方法直射日光、高温・多湿を避けて保存して下さい発売元エスケー石鹸(株)広告文責株式会社 クロスコム0797-69-6860商品情報合成界...
いいもの特撰館
4,312円(税込) (送料込) (カード利用可)
レビュー件数: 2 平均評価: 4.5


Amway アムウェイ スプリーデント 薬用フッ素配合 ハミガキ 医薬部外品 200g 3個セット
追跡番号あり発送 送料込み
<コード:1480>デンタルケアアムウェイ スプリーデント 薬用フッ素配合 ハミガキ 医薬部外品 200g歯にやさしい研磨剤配合で汚れや黄ばみをしっかりと除去しながら、薬用成分フッ素(フッ化物)配合で、むし歯の発生や進行を抑えます。また、ニュートリライト農場で栽培されたペパーミントを使用したオイルがお口の中をさわやかにします。 <医薬部外品>《内容量:200g×3本》【広告文責】・お問い合わせ先:...
bi-sai
6,204円(税込) (送料込) (カード利用可)
レビュー件数: 2 平均評価: 3


【選べる1〜10個セット】スーパースマイル 50g 医薬部外品 ホワイトニング 歯周病予防 お試しサイズ 携帯用 歯ぐきケア 薬用歯磨き
歯科先進国で選ばれるブランド
商品情報内容量:50g区分:医薬部外品製造国:アメリカ製造販売元:株式会社クチュール広告文責株式会社Office KannaTEL:082-847-2414【ポイント5倍当店バナーよりエントリー必須】【選べる1〜10個セット】スーパースマイル 50g 医薬部外品 ホワイトニング 歯周病予防 お試しサイズ 携帯用 歯ぐきケア 薬用歯磨き 歯科先進国で選ばれるブランド 商品説明 ・ホワイトニング施術の...
歯科と日用雑貨 オフィスKanna
2,420円(税込) (送料込) (カード利用可)
レビュー件数: 2 平均評価: 4



【365日休まず営業しております】
商品詳細 商品名 薬用 デンタルポリスDX(DENTAL POLIS DX) 内容量 (約)80g 成分 ● 研磨剤:歯磨用リン酸水素カルシウム、含水ケイ酸、リン酸マグネシウム ● 湿潤剤:ソルビット液、濃グリセリン ● 溶剤:精製水、エタノール ● 増粘剤:無水ケイ酸 ● 矯味剤:プロポリスエキス、カンゾウエキス ● 粘結剤:カラギーナン、カルボキシメチルセルロースナトリウム ● 発泡剤:ラリウ...
健康美容用品専門店Frontrunner
5,368円(税込) (送料込) (カード利用可)
レビュー件数: 2 平均評価: 4.5


薬用ぎょくせい80 115g15本セット歯槽膿漏が気になる方におすすめ致します
歯周病(歯肉炎、歯周炎)予防
サンスター薬用はみがき粉 薬用ぎょくせい80 歯周病 歯槽膿漏予防 マウスケア 口臭 口内殺菌 引き締め血行 抗炎症 歯がツルツル いい匂い SUNSTAR 歯周病の気なる方に おすすめ 商品です。 塩 と 生薬 歯周病予防 や 歯肉炎 歯周炎 の気なる方に。毎日のオーラルケアーにおすすめ致します 薬用歯磨き の 4種類の薬用成分 で 歯周病を予防 します。 塩化ナトリウムで、歯ぐきを引き締め ...
サウス&ビューティー
17,800円(税込) (送料込) (カード利用可)
レビュー件数: 2 平均評価: 4.5




ライオン チェックアップ ジェル ミント 歯磨きジェル 75g 10本セット
LION Check Up gel フッ化物配合ジェル フッ素濃度1450ppm 虫歯予防歯磨きジェル 歯科医院専売品
■商品説明 いつもの歯磨きに加えて使用するフッ化物配合ジェル。 フッ化ナトリウム1450ppmF配合、フッ素が歯面に滞留して口腔内のすみずみまで広がりやすいソフトジェルタイプ。 フッ素滞留性を高めた独自処方のカチオン化セルロース配合、少ない泡立ちでやさしい香味なので少量での洗口が可能です。 ■分類 歯磨きジェル ■容量 75g×10本 ■主な成分 ソルビット液(湿潤剤)、PG(湿潤剤)、香料(香味...
歯科用オーラルケアの専門店
5,500円(税込) (送料込) (カード利用可)
レビュー件数: 2 平均評価: 4.5


【特典あり・まとめ買い割引】アパガード スモーキン 105g ヤニ汚れ/黄ばみケア/ホワイトニング歯磨き粉//爽快感アップ/オーラルケア
ヤニや着色汚れが気になる方に。自然な白さを意識した口腔ケアアイテム。
【まとめ買いでお得!】アパガード スモーキン 105g 予防 ホワイトニング ヤニ 黄ばみ 歯磨き粉 オーラルケア 送料無料 アパガード スモーキン 105g 予防 ホワイトニング ヤニ 黄ばみ 歯磨き粉 オーラルケア 送料無料 5 こちらもおすすめ! 【まとめ買いでお得!】 アパガード エクストラミント 105g 1,350円? 送料無料 【まとめ買いでお得!】 アパガード Mプラス 130g ...
美とくらし
1,550円(税込) (送料込) (カード利用可)
レビュー件数: 2 平均評価: 5




【業界初「ファインバイオアパタイト80%」配合】今までにないホワイトニングパウダー!キシリトール配合で頑固な黄ばみ、歯垢、口臭もすっきり。
商品名メディカルホワイトナノ80・5袋セット+1袋 内容量15g×6袋 成 分〈清掃剤〉ヒドロキシアパタイト〈甘味料〉キシリトール〈清涼剤〉メントール 〈食品原料のみ使用〉 使用期限未開封で2年間、開封後はなるべく早く使い切るようにして下さい。 こんな方におすすめ ・より高い濃度のアパタイト製品を探している方 ・ホワイトニングをしている方 ・歯磨き粉がしみる方 ・口臭、歯垢が気になる方 ・コー...
ホスピタリティShop
5,720円(税込) (送料込) (カード利用可)
レビュー件数: 2 平均評価: 4.5




シュミテクト コンプリートワンEX トゥルーホワイト 歯周病ケア 送料無料 自由に選べる 1個 3個 6個
Haleonジャパン シュミテクト 歯周病ケア 高濃度フッ素配合 歯周病ケア 口臭予防 ヘイリオン 歯磨き粉 歯肉炎 むし歯 薬用ハミガキ 知覚過敏 ホワイトニング
■コンプリートワンEX 商品説明 ●薬用ハミガキ シュミテクト コンプリートワンEX ●知覚過敏の人のことを考え、冷たいものや熱いものなどの刺激によって歯がシミる不快感や痛みを防ぐ、知覚過敏ケアを考えたオールインワンハミガキ。7つの働きがひとつに。シミるのを防ぐ、歯周病予防(*1)、歯を白くする(*2)、ムシ歯予防、口臭防止、口中クリーン、歯石の沈着予防。[*1:歯肉炎、歯周炎の総称][*2:ブラ...
ネクストプライス楽天市場店
1,430円(税込) (送料込) (カード利用可)
レビュー件数: 2 平均評価: 5




【まとめ買い10本セット】さよなら 歯の着色汚れイオンの力で浮かせて落とすセルフケア用 ライオン ブリリアントモアw 歯 ホワイトニング 自宅 おすすめ
商品名ブリリアントモア W ダブル 90g × 10本 セット シトラスミント フレーバー 製品特徴歯科用 効能・効果 歯を白くする 口臭 の 予防 ムシ歯 の発生と進行の 予防 タバコ の ヤニ除去 口の中を浄化する商品区分歯磨き粉 医薬部外品 特徴毎日のセルフケアに 歯の着色汚れ(ステイン)の蓄積を防ぎます。 クリーニング や ホワイトニング をした後のケアに 矯正中や矯正装置を外した後などの...
からだにやさしい製品館
8,900円(税込) (送料込) (カード利用可)
レビュー件数: 2 平均評価: 4.5




シャボン玉 薬用 せっけんハミガキ 80g 3個セット シャボン玉石けん 歯磨き粉 ミント
歯肉炎・歯周炎を予防し、口臭も防ぎます
シャボン玉 薬用 せっけんハミガキ 80g 3個セット シャボン玉石けん 歯磨き粉 ミント 歯肉炎・歯周炎を予防し、口臭も防ぎます ●「天然塩」が歯ぐきをひきしめて歯肉炎・歯周炎を予防し、口臭も防ぎます。●自然派のこだわり成分。発泡剤にラウリル硫酸ナトリウムなどの「合成界面活性剤」は使用せず「無添加石けん」を使用。お口にやさしく、歯みがきをした後、味覚が変化しません。●しっかりとブラッシングできる...
World NEXT
1,970円(税込) (送料込) (カード利用可)
レビュー件数: 2 平均評価: 5




【あす楽】(3本セット)薬用 なた豆はみがきプラス 120g 歯磨き粉 はみがき粉 歯肉炎 歯周病 歯槽膿漏 口臭 歯垢除去 ホワイトニング プラセス製薬 送料無料 ギフト プレゼント
歯肉炎、歯周炎、口臭の予防に効果の期待できる薬用ハミガキ
(商品名) 3本セット 薬用 なた豆はみがきプラス 120g (商品説明) なた豆パワーで口腔内スッキリ! 古くから、膿とり豆として知られている「なた豆」 その、なた豆エキスを配合した歯みがき剤です。 口腔内の環境を整えるキシリトール・ヒドロキシアパタイト・ 茶葉エキス等をプラスしました。 磨いた後の爽快感をぜひ体感してください。 このようなお悩みのある方に、特にオススメです! ・歯肉炎(齦)の予...
ESCO SHOP
4,200円(税込) (送料込) (カード利用可)
レビュー件数: 2 平均評価: 3.5
![【2個】 アクティブワオ Active Wow 活性炭 歯磨き粉 ホワイトニング チャコールパウダー [スペアミント] 20g アクティブ ワオ 歯 ホワイトニング 歯のホワイトニング ホワイトニングパウダー Activated Charcoal Teeth Whitening Powder, Spearmint](https://thumbnail.image.rakuten.co.jp/@0_mall/americana/cabinet/misako_y/302004-2.jpg?_ex=128x128)



オーガニックココナッツのチャコールパウダー歯磨き粉!
一緒に購入されることが多いアイテムCrest クレスト 歯磨き粉 プロヘルス 2,990円オールドスパイス Old Spice ジェント4,490円クレスト 3Dホワイト ウルトラ 歯みがき粉 3,190円お得な2個セットです! オーガニックのココナッツ由来の活性炭パウダーの歯磨き粉です。 【商品】アクティブワオ Active Wow 活性炭 歯磨き粉 ホワイトニング チャコールパウダー [スペア...
アメリカーナ Americana
6,390円(税込) (送料込) (カード利用可)
レビュー件数: 2 平均評価: 5

3個セット【公式】NOILA-S 歯磨き粉 50g|息を浄化し、歯に本来の輝きを。銀イオンで原因菌をリセットする、集中プロテクト・ペースト|マイルドハーブ|低刺激 日本製
3個セット/銀イオン配合 口内除菌・抗菌/低研磨 ・低刺激 ・低発泡でしっかり磨く/口コミサイト 2年連続1位 受賞/歯の美意識が高いアメリカ、アメリカ歯科医師会にて低研磨試験済
銀イオンで口内除菌 NOILA-S歯磨き粉のご紹介 ■銀イオンを配合することにより、口のにおい、ヌメり、ネバつきを除去。1時間以上の効果継続を確認しております。 ■アメリカ歯科医師会の基準値をクリアした調整低研磨・ステイン除去力は歯を傷つけることなく口内を清潔に保ちます。 ■天然由来成分98%は口内の乾燥を防ぎ、唾液の分泌を助けます。口内を潤すことで菌を抑制し、口内本来の抗菌環境を構築します。 成...
NOILA楽天市場店
6,600円(税込) (送料込) (カード利用可)
レビュー件数: 2 平均評価: 5


5本セット ピーアップ バイオペースト はみがき粉 オーラルケア 歯周病対策 口臭 ホワイトニング P-UP BIOPASTE
お得な5本セット
ピーアップ バイオペースト 口腔内細菌は万病の元 口内環境を整え、健康寿命を延ばす 全成分が天然由来で、合成界面活性剤、フッ素、研磨剤、パラベン、香料等は一切使用していません。 研磨剤を使用せずとも主成分であるP-UPバイオミネラルの優れた洗浄力が汚れを落とし、使用後はイオンコーティングにより歯垢や歯石の再付着を防ぎます。 また、高い還元力を有し、口臭による悪臭の予防やインフルエンザ、ノロウィルス...
ボーテ&サンテマルシェ
5,500円(税込) (送料込) (カード利用可)
レビュー件数: 2 平均評価: 5




【送料無料の4個セット】【三宝製薬】デンタパールW 108g (※医薬部外品)
◆特 長◆デンタパールWは、“フッ素入り歯みがき剤"(青色ペースト)とハイドロキシアパタイトの前駆物質“β-TCP(基剤)入り歯みがき剤"(白色ペースト)を2重のチューブに充填し、歯を白くすること、歯周病(歯肉炎・歯槽膿漏)やむし歯を予防すること、をめざした新しい発想の歯みがき剤です。◆メーカー(※製造国または原産国)◆三宝製薬株式会社※製造国または原産国:日本◆効能・効果◆歯を白くする、むし歯の...
あんしん通販 リリーフ
6,029円(税込) (送料込) (カード利用可)
レビュー件数: 2 平均評価: 5




アメリカで人気の歯磨き粉 まとめ買い お得 セット Crest 3D White Brilliance Vibrant Peppermint Toothpaste 4.6 oz
商品情報 商品名 Crest 3D White Brilliance Vibrant Peppermint Toothpaste 内容量 130g(4.6oz) 保存方法 高温多湿や直射日光を避け、涼しい場所に保管してください。 使用方法 一回のご使用で、通常成人男性の小指第一関節程度を目安にしてください。 使い続ける事で、通常の歯磨き粉では落とせなかったシミや汚れを効果的に除去します。最も効果的...
TW Direct
3,470円(税込) (送料込) (カード利用可)
レビュー件数: 2 平均評価: 3




【まとめ買い】ORALPEACE オーラルピース クリーン&ホワイト 80g 3本セット 歯磨き粉 口臭
【無料ギフトラッピング対応可】
「ネオナイシン-eR」とハイドロキシアパタイトのW配合 日本発の乳酸菌バイオテクノロジー研究から生まれた、お口の中を清潔にしながら潤いを保ち、白く健康な歯までをトータルケアする*、食べれる成分とオーガニック成分のやさしいホワイトニング・オーラルケア健康ジェル「オーラルピース クリーン&ホワイト(オーガニック・ホワイトニング・研磨剤フリー歯磨きジェル)」は、世界一の安全性と臨床効果を追求し、九州大学...
エムコスメスタイル
4,950円(税込) (送料込) (カード利用可)
レビュー件数: 2 平均評価: 5


【100円OFFクーポン有】ライオン DENT. システマ Systema 薬用 歯間ジェル +フッ素 選べる2〜10個 (20ml/個)
歯間ブラシやワンタフトブラシと一緒に使用して、歯周病になりやすい部位を集中的にケア
商品サイズ (幅×奥行×高さ) :25mm×46mm×85mm 内容量:20ml [効能効果] IPMP*1がバイオフォルム*2を効果的に浸透・殺菌して歯肉炎を予防します。さらさら状態のジェルがゲル化して、薬用成分が長く留まります。 *1 IPMP:イソプロピルメチルフェノール *2 口腔内の細菌のかたまりである歯垢(プラーク) ●歯周病は歯肉炎・歯周炎の総称です [成分]モノフルオロリン酸ナトリ...
バリュープライスオンラインストア
1,360円(税込) (送料込) (カード利用可)
レビュー件数: 2 平均評価: 5
![【ふるさと納税】<選べる容量>歯周病ケア 歯磨き粉 ペリオテクト シトラスミックス味 ホワイトエッセンス [医薬部外品] | IPMP CPC 歯周病 歯槽膿漏 予防 対策 研磨剤なし 黄ばみ ヤニ取り 茶渋 美白 自宅 簡単 歯科 歯医者 歯磨き 歯みがき粉 ブレスケア](https://thumbnail.image.rakuten.co.jp/@0_mall/f141500-sagamihara/cabinet/10269925/110133-30064267-01.jpg?_ex=128x128)



歯周病にサヨナラ
IPMP と CPC のダブル成分を配合した歯周病ケア歯磨き粉。 歯周病菌を殺菌し、歯周炎・歯肉炎を防止します。 名称 歯周病ケア 歯磨き粉 ペリオテクト シトラスミックス味 内容量 1本あたり:85g 成分 ソルビット液・濃グリセリン(湿潤剤)、精製水・エタノール(溶剤)、無水ケイ酸(粘度調整剤)、ポリビニルピロリドン・トコフェロール酢酸エステル・ラウロイルサルコシンナトリウム・フッ化ナトリウム...
神奈川県相模原市
9,000円(税込) (送料込) (カード利用可)
レビュー件数: 2 平均評価: 4


竹炭ハミガキ 130g 6本セット ハミガキ粉 口臭予防 虫歯予防 ステイン 清掃作用
とことん竹炭にこだわった、はみがき!
竹炭ハミガキ 130g 6本セット ハミガキ粉 口臭予防 虫歯予防 ステイン 清掃作用 とことん竹炭にこだわった、はみがき! ●超微粒子シリカと竹炭の歯垢、ステイン清掃作用により光沢のある白い歯にします。●竹炭が口臭の元を吸着除去し、口臭を予防します。●主な成分 竹炭(食用炭)、超微粒子シリカ、ピロリン酸ナトリウム、緑茶エキス、ビタミンC、テアニン、竹酢液、スペアミント油、ムクロジエキス、甘草エキ...
World NEXT
3,300円(税込) (送料込) (カード利用可)
レビュー件数: 2 平均評価: 5




【選べる3本セット】オーラルケア◆ ホームジェル65g◆ (う蝕予防ジェル) (ノンフレーバー・グレープ・ストロベリー・ミント・オレンジ・ラムネ・) 送料無料 歯磨き粉 キッズ
家庭でできるフッ素習慣
商品情報商品区分:医薬部外品製造国:日本発売元、製造元、輸入元又は販売元:(株)オーラルケア広告文責:オフィスKanna TEL:082-847-2414【選べる3本セット】オーラルケア◆ ホームジェル65g◆ (う蝕予防ジェル) (ノンフレーバー・グレープ・ストロベリー・ミント・オレンジ・ラムネ・) 送料無料 歯磨き粉 キッズ 家庭でできるフッ素習慣 家庭でできるフッ素習慣 むし歯予防に大切な歯...
歯科と日用雑貨 オフィスKanna
2,740円(税込) (送料込) (カード利用可)
レビュー件数: 2 平均評価: 5




パックス ナチュロン 石けんはみがき 120g 10個セット 歯みがき粉 歯磨き粉 ハミガキ粉 泡立ちひかえめ 口臭 歯石 歯 オーラルケア 口腔ケア 太陽油脂
送料無料!代引き無料!(沖縄・離島は別途送料) 10個セットの販売です 爽快ハッカタイプ! 100%自然由来成分! 泡立ちひかえめクセになる! ●石油由来原料・合成界面活性剤・鉱物油・合成ポリマー・水酸化アルミニウム・合成防腐剤・合成香料・合成着色料・プロピレングリコール・サッカリンはすべて無添加です。 ●磨いた後も味がわかる!石けん成分は口腔内の粘膜や舌(味蕾)に吸着しにくく、口をゆすぐとサッと...
即納ドラッグ 金太郎SHOP
4,298円(税込) (送料込) (カード利用可)
レビュー件数: 2 平均評価: 5


お口 健康 サポート キシリトール 送料無料
商品情報商品名プロスペック 歯みがきペースト香味ダブルミント成分薬効成分:0.2%フッ化ナトリウム(フッ素900ppm)、 グリチルリチン酸ジカリウム、塩酸クロルヘキシジン製造元TOA株式会社区分日本製・医薬部外品広告文責株式会社Glood roi070-8435-9613【3個セット】GC ジーシー プロスペック 歯みがきペースト 65g 歯磨き粉 ハミガキ粉 フッ素 900ppm ミント 歯科...
くらし応援本舗 楽天市場店
1,680円(税込) (送料込) (カード利用可)
レビュー件数: 2 平均評価: 5




【定形外郵便送料無料】プレミアムホワイト100g歯科医院専用MADE IN JAPAN【premium White】ピヤス
【ポリリン酸ナトリウム配合 歯を白く】
薬用ハミガキ プレミアムホワイト 内容量:100g 日本製 ホワイトニング歯みがきペースト ●発送までに2週間くらいかかる場合がございます。
いいもん 楽天市場店
1,767円(税込) (送料込) (カード利用可)
レビュー件数: 2 平均評価: 3




エビス EP-0131 ゼロプレミアムケアズ リフレッシュ 90g 3個セット ハミガキ 歯磨き粉 口臭 歯周病 予防 対策 コスメ まとめ買い 送料無料
濃密ミクロ泡が歯の凹凸に入り込む 清涼感あふれる爽やかな香り 「気分に合わせて」選ぶハミガキ 薬用トータルケア シャイン・シトラスの香り 高濃度 フッ素 研磨剤無配合 歯の美白
エビス EP-0131 ゼロプレミアムケアズ リフレッシュ 90g 3個セットでの販売です。 時短みがきでも、磨き残しゼロへ。 キメ細かな泡が磨き始めた瞬間に広がる濃密ミクロ泡処方。 研磨剤無配合で歯や歯ぐきに優しい。 1洗浄剤がステインを浮き上がらせて除去、歯面をコーティングして汚れをつきにくくする。 2薬用成分が隅々まで広がり口臭、歯周病(歯周炎・歯肉炎の総称)を予防。 3高濃度フッ素で歯質を...
食品・雑貨の総合通販 DON-SHOP
2,380円(税込) (送料込) (カード利用可)
レビュー件数: 2 平均評価: 4.5
